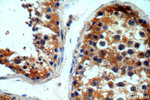
ITPR1 Antibody in Immunohistochemistry (Paraffin) (IHC (P))

Search
Proteintech
ITPR1 Polyclonal Antibody
{{$productOrderCtrl.translations['antibody.pdp.commerceCard.promotion.promotions']}}
{{$productOrderCtrl.translations['antibody.pdp.commerceCard.promotion.viewpromo']}}
{{$productOrderCtrl.translations['antibody.pdp.commerceCard.promotion.promocode']}}: {{promo.promoCode}} {{promo.promoTitle}} {{promo.promoDescription}}. {{$productOrderCtrl.translations['antibody.pdp.commerceCard.promotion.learnmore']}}
产品信息
19962-1-AP
种属反应
已发表种属
宿主/亚型
分类
类型
抗原
偶联物
形式
浓度
规格
纯化类型
保存液
内含物
保存条件
运输条件
产品详细信息
The antibody has no cross reaction with ITPR2 and ITPR3.
靶标信息
Intracellular channel that mediates calcium release from the endoplasmic reticulum following stimulation by inositol 1,4,5-trisphosphate. Involved in the regulation of epithelial secretion of electrolytes and fluid through the interaction with AHCYL1. Plays a role in ER stress-induced apoptosis. Cytoplasmic calcium released from the ER triggers apoptosis by the activation of CaM kinase II, eventually leading to the activation of downstream apoptosis pathways.
仅用于科研。不用于诊断过程。未经明确授权不得转售。
生物信息学
蛋白别名:
Inositol 1,4,5 trisphosphate receptor; inositol 1,4,5-triphosphate receptor 1; inositol 1,4,5-triphosphate receptor, type 1; Inositol 1,4,5-trisphosphate receptor; Inositol 1,4,5-trisphosphate receptor type 1; Inositol 1,4,5-trisphosphate-binding protein P400; Inositol 1,4,5-trisphosphate-gated calcium channel ITPR1; InsP3R type I; insP3R1; InsP>3
基因别名: ACV; CLA4; D6Pas2; ENSMUSG00000072853; Gm10429; I145TR; InsP3R; INSP3R1; IP3R; IP3R1; Itpr-1; ITPR1; opt; P400; Pcd6; Pcp-1; Pcp1; PPP1R94; SCA15; SCA16; SCA29
UniProt ID: (Human) Q14643, (Mouse) P11881, (Rat) P29994
Entrez Gene ID: (Human) 3708, (Mouse) 16438, (Rat) 25262